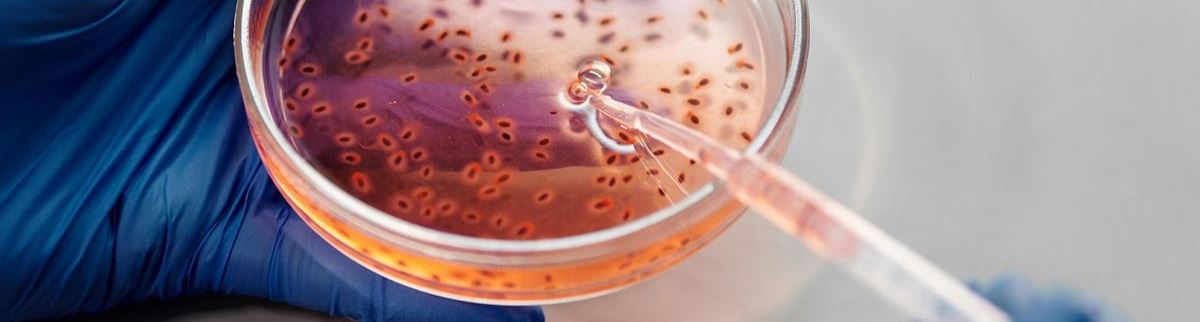
Bactéries dans un bol

Des pathogènes aux probiotiques : le monde diversifié des bactéries
Qu'est-ce qu'une bactérie ?
Les bactéries sont des organismes unicellulaires sans noyau cellulaire. Cela signifie qu'elles sont microscopiquement petites et sont constituées d'une seule cellule, contrairement aux organismes multicellulaires tels que les plantes et les animaux. L'absence de noyau cellulaire implique que l'ADN des bactéries est libre dans le cytoplasme, ce qui rend leur structure plus simple que celle des organismes plus complexes.
C'est un terme que nous connaissons tous et que nous utilisons régulièrement (au sens propre comme au figuré 😉). Mais qu'est-ce qu'une bactérie exactement ?
Nous avons souvent tendance à penser que les bactéries sont nuisibles, mais en réalité, la plupart des bactéries sont inoffensives. En fait, elles contribuent à un environnement meilleur et à une santé améliorée. Pensez par exemple aux bactéries qui maintiennent l'équilibre de notre flore intestinale. Elles sont non seulement bénéfiques pour notre corps, mais elles constituent également une addition précieuse à notre vie quotidienne sous forme de probiotiques. De plus, elles jouent un rôle crucial dans le traitement des déchets et peuvent même être intégrées dans des produits de nettoyage pour aider naturellement à l'assainissement.
Bien sûr, il existe aussi des bactéries nocives que l'on appelle pathogènes.
À quoi ressemble une bactérie ?
À l'œil nu, les bactéries sont invisibles pour nous. Ce n'est que lorsque nous les observons sous un microscope que se révèle un monde de diversité et de complexité. Les bactéries sont classées dans différentes catégories morphologiques en fonction de leur forme et de leur structure. Voici quelques formes courantes :
- La forme sphérique (coccus) : Ces bactéries ont une structure ronde ou sphérique. Un exemple est le staphylocoque, souvent trouvé en amas.
- La forme allongée en bâtonnet (bacille) : Les bacilles ont une forme allongée et cylindrique. Ils peuvent être isolés ou en chaînes. Un exemple bien connu est le lactobacille, bénéfique pour la flore intestinale.
- La forme en virgule : Les bactéries ayant une structure en virgule sont moins fréquentes mais restent une catégorie importante. Un exemple est Vibrio cholerae, l'agent responsable du choléra.
- La forme spiralée : Ces bactéries ont une structure spiralée ou hélicoïdale. Un exemple est Spirillum volutans.
Chaque forme a ses propres caractéristiques uniques et peut remplir différentes fonctions dans divers environnements. Cette diversité de forme contribue à l'extraordinaire capacité d'adaptation des bactéries et à leur capacité de prospérer dans des environnements variés, allant des profondeurs de l'océan à nos propres corps.

Comment se reproduit une bactérie ?
Les bactéries se reproduisent par division cellulaire, un processus qui passe par cinq phases. Tout d'abord, la réplication de l'ADN se produit, suivie par la phase d'étirement cellulaire, où la cellule s'étire. Ensuite, une encoche se forme dans la paroi cellulaire, permettant à la cellule de se diviser en deux filles identiques. Chaque fille se développe pour devenir une cellule adulte. Ce qui est remarquable, c'est la vitesse à laquelle cela se produit : dans des conditions idéales, une bactérie se divise toutes les 20 minutes. Si vous laissez environ 100 bactéries le matin à 8 heures, il pourrait y en avoir jusqu'à 409 600 vers midi. Cela souligne la reproduction rapide des bactéries et souligne l'importance de mesures d'hygiène efficaces.
Quelles sont les conditions idéales pour les bactéries ?
Les bactéries prospèrent dans des conditions spécifiques, qui, étonnamment, ne sont pas si différentes de celles dont nous avons besoin en tant qu'êtres humains. Elles se développent le mieux dans des environnements humides, où l'eau est facilement disponible. Une température agréable, ni trop froide ni trop chaude, est également favorable à leur croissance. De plus, les bactéries ont besoin de nutriments pour survivre, ce qui signifie qu'elles préfèrent les environnements où du matériel organique est présent. Enfin, elles évitent les environnements trop acides, car cela peut inhiber leur croissance.
Mais comment pouvons-nous éviter ces conditions idéales pour les bactéries ? La réponse réside dans des mesures efficaces de nettoyage et d'hygiène. En nettoyant soigneusement, nous éliminons les sources de nourriture des bactéries, ce qui entrave leur croissance. Il est essentiel de bien rincer et sécher les surfaces, afin de minimiser voire d'éliminer tout résidu d'humidité, car les bactéries se développent dans des environnements humides.
De plus, il est important d'investir dans des produits de nettoyage spécifiquement formulés pour éliminer les bactéries et pour désinfecter les surfaces en profondeur. En adoptant ces pratiques, nous pouvons efficacement contrôler la croissance des bactéries et maintenir un environnement hygiénique, que ce soit à la maison ou au travail.